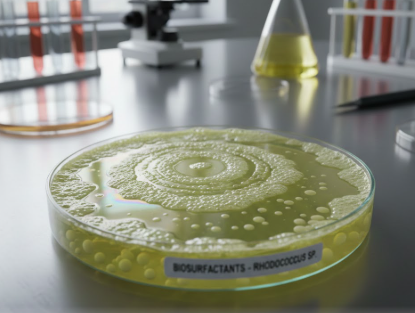

The report "Biosurfactants Market by Type [Glycolipids (Sophorolipids, Rhamnolipids) and Lipopeptides], Application (Detergent, Personal Care, Food Processing, Agricultural Chemicals), and Region - Global Forecast to 2030", The biosurfactants market size was USD 1.65 billion in 2025 and is projected to reach USD 2.89 billion by 2030, at a CAGR of 11.79%, during the same period. The report provides a comprehensive analysis of the global industry, including market size, share, demand, industry development status, and biosurfactants market trends with forecasts for the next few years.
Browse in-depth TOC on "Biosurfactants Market"
195 - Tables
60 - Figures
280 - Pages
Download PDF Brochure: https://www.marketsandmarkets.com/pdfdownloadNew.asp?id=163644922
The detergent and cleaning industries primarily utilize biosurfactants due to their versatility. This versatility is evident in their high cleaning effectiveness and their compatibility with a wide range of formulations, including liquid detergents, dishwasher liquids, and fabric cleaners. Biosurfactants have been of great importance in applications such as these, as they exhibit excellent foaming, emulsification, and biodegradability, ensuring effective stain removal without harming the environment. As the global community becomes increasingly interested in eco-friendly and plant-based cleaning products, the use of sophorolipids and rhamnolipids is gradually becoming a trend among producers to enhance cleaning effectiveness and address sustainability requirements. The current trend towards using sustainable household and industrial cleaning products aims to further solidify the position of biosurfactants in the detergent industry. The growing interest of consumers in non-toxic, high-performance, and natural products is expected to further drive market growth, which will be supported by advancements in fermentation technology and formulation chemistry.
The rhamnolipid segment is projected to be the fastest-growing type in the biosurfactants market during the forecast period.
The rhamnolipid segment is projected to witness the highest CAGR in the biosurfactants market during the forecast period. Rhamnolipids have a high emulsification and dispersing property, and hence manufacturers can develop high performance formulas to use in industrial and domestic cleaning processes. They are highly versatile in their applications across the oilfield recovery sector, agriculture, and industrial detergents due to their ability to remain stable over a wide range of temperatures, pH levels, and salinity. This high performance, in combination with low toxicity and full biodegradability, is what has made them even more widely used as a sustainable alternative to synthetic surfactants. Furthermore, the continuous improvement of fermentation activity and downstream purification is reducing the production cost, thereby increasing the commercial feasibility of rhamnolipids. The fusion of technical efficiency and environmental friendliness remains a key factor in making this segment one of the major growth drivers in the global biosurfactants market.
Request Sample Pages: https://www.marketsandmarkets.com/requestsampleNew.asp?id=163644922
The detergent application segment is projected to account for the largest share in the biosurfactants market during the forecast period.
The rising demand for clean, environmentally friendly products is driven by the increasing awareness among consumers of the importance of sustainability and skin safety. Biosurfactants play a crucial role in the development of household and industrial detergents, as they enhance cleaning, foaming, and emulsification properties while being biodegradable and non-irritating. They are suitable for use as next-generation detergents due to their performance and compatibility with a broad range of formulations, which are particularly demanding in the presence of hard water. The growth of the urban population and increased awareness of environmental concerns, particularly in Europe and North America, will drive faster demand growth for biosurfactant-based detergents. Further innovation in formulation chemistry and process optimization will strengthen them as a sustainable cleaning solution in the global market.
North America was the second-largest region in the global biosurfactants market in terms of value in 2024.
North America was the second-largest biosurfactants regional market in 2024, in terms of value. The high demand for bio-based and biodegradable surfactants has been driven by the significant presence of personal care, household cleaning, and agricultural chemicals in the region. This has been further boosted by increasing regulatory pressure to withdraw petrochemical-based surfactants and growing consumer demand for more environmentally friendly surfactants, driving a shift towards the use of biosurfactant products. To improve product sustainability and performance further, manufacturers in North America are increasingly adopting fermentation-based production technologies and renewable feedstocks. The increased attention to ESG compliance, green chemistry programs, and sustainability objectives is encouraging organizations to incorporate biosurfactants into the product recipes of various end-use markets. With big brands in the area already developing clean-label formulations and implementing the principles of the circular economy, biosurfactants are becoming an enabler of sustainable change in the North American markets.
The key players profiled in the report include Evonik Industries AG (Germany), Shaanxi Deguan Biotechnology Co., Ltd (China), Biotensidon GmbH (Germany), Saraya Co., Ltd. (Japan), Allied Carbon Solutions Co., Ltd. (Japan), Daqing VICTEX Chemical Industries Co., Ltd. (China), Stepan Company (US), Holiferm Limited (UK), Dow Inc. (US), Solvay S.A. (Belgium), Givaudan SA (Switzerland), AGAE Technologies, LLC (US), Biosurfactants LLC (US), Kaneka Corporation (Japan), and Kemin Industries, Inc. (US).
Why Purchase This Report:
➥ Gain a strategic vantage on competitors to sharpen your marketing and sales strategy
➥ Spot emerging disruptors with early-stage momentum and product innovation
➥ Identify target partners or clients in high-growth segments for outreach and collaboration
➥ Shape tactical decisions based on where leading companies are investing and expanding
➥ Support licensing, M&A or partnership planning with robust evidence
➥ Equip internal or client-facing presentations with high-quality validated insights
Request Customization: https://www.marketsandmarkets.com/requestCustomizationNew.asp?id=163644922
Table of Contents - Major Key Points:
1. Study Coverage
2. Executive Summary
3. Research Methodology
4. Global Production Analysis
5. Value Chain and Supply-Chain Analysis
6. Market Dynamics
7. Competition by Manufacturers
8. Whey Market Segmentation, By Type
9. Whey Market Segmentation, By Application
10. Regional Analysis
11. Corporate Profile
12. Conclusion...